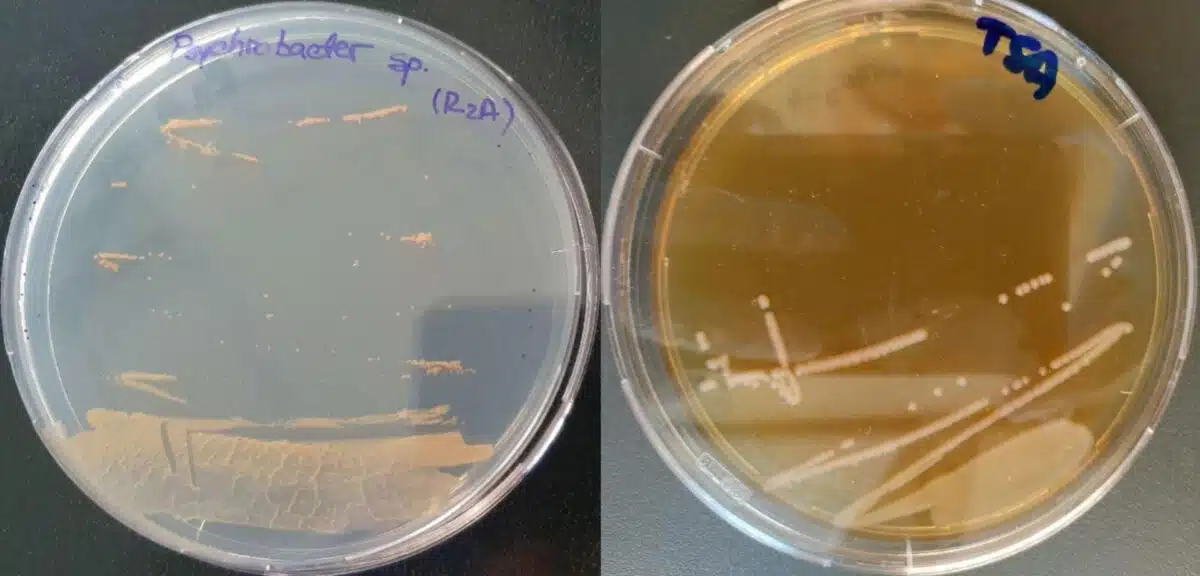
Psychrobacter Sp. Sc65a.3 Colonies Cultured On Agar Plates After Isolation From Ancient Cave Ice.

Found in an Ice Cave, This Ancient Bacterium Holds 100+ Resistance Genes
A bacterial strain extracted from 5,000-year-old ice in Romania’s Scărișoara Ice Cave has proven both resistant to multiple modern antibiotics and capable of inhibiting dangerous superbugs.
Antibiotic resistance already accounts for more than a million deaths worldwide each year. Often portrayed as a modern crisis driven by the overuse of drugs, it is in fact part of a much older evolutionary struggle between microorganisms.
The new study, led by researchers from the Institute of Biology Bucharest (IBB) of the Romanian Academy, suggests that ice caves and other frozen ecosystems may preserve microbial traits that could inspire new treatments or intensify current public health challenges.
A 25-Meter Reveals Hidden Genetic Arsenal
To reach the ancient microbes, the team drilled a 25-meter ice core from the Great Hall of Scărișoara Ice Cave, which contains one of the largest and oldest perennial underground ice blocks on Earth.
After isolating bacterial strains from the ice, researchers performed genome sequencing to identify genes linked to cold adaptation and antimicrobial activity. According to the study published in Frontiers in Microbiology, the strain identified as Psychrobacter SC65A.3 carries more than 100 resistance-related genes.
Despite being frozen for 5,000 years, the bacterium showed resistance to several commonly used antibiotics prescribed for lung, skin, blood, and other infections. As microbiologist Cristina Purcarea stated that:
the strain “shows resistance to multiple modern antibiotics and carries over 100 resistance-related genes.”
A Bacterium Capable of Suppressing Superbugs
The findings from the cave did not end with resistance. Laboratory tests showed that Psychrobacter SC65A.3 can inhibit the growth of several major antibiotic-resistant superbugs. As stated by the researchers:
” it can also inhibit the growth of several major antibiotic-resistant ‘superbugs’ and showed important enzymatic activities with important biotechnological potential.”
Bacteria belonging to the Psychrobacter genus are adapted to survive in extreme cold, conditions that drive genetic specialization and diversification. Purcarea noted that the strain produces unique enzymes and antimicrobial compounds that could inspire new antibiotics and industrial applications.
This dual capacity, harboring resistance genes while producing antimicrobial substances, places the bacterium in a singular position between threat and opportunity.
Dormant Genes Released
The study also points to a broader environmental concern. Frozen ecosystems can function as long-term reservoirs of resistance genes preserved for millennia in stable conditions.
“If melting ice releases these microbes, these genes could spread to modern bacteria, adding to the global challenge of antibiotic resistance,” explained Purcarea.
If strains such as Psychrobacter SC65A.3 spread or transfer their resistance genes to contemporary bacteria, the global antibiotic resistance crisis could deepen.
First Appeared on
Source link